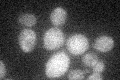
YJL165C
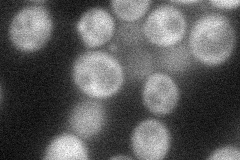
YJL165C
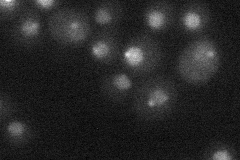
YJL165C
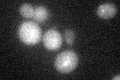
YJL165C

View description
Putative protein kinase; overexpression increases sodium and lithium tolerance, whereas gene disruption increases cation and low pH sensitivity and impairs potassium uptake, suggesting a role in regulation of Trk1p and/or Trk2p transporters
Localization:
Intensity:
Fold change:
Significance:
-
C’ GFP library in SD
below threshold17.61 -
N' NOP1pr-GFP in SD
cytosol,punctate43.8028 -
N' TEF2pr-mCherry in SD
punctate,nucleus10.6807 -
N' NATIVEpr-GFP in SD

punctate,nuclear periphery25.1934 -
N' TEF2pr-VC and Cyto-VN in SD

#N/A0 -
C’ GFP library in SD+DTT
cytosol15.910.9No -
C’ GFP library in SD+H2O2

cytosol17.981.02No -
C’ GFP library in Starvation Media

cytosol14.670.83No -
C’ GFP library on the background of Pup2-DaMP

below threshold -
C’ GFP library on the background of CCT mutant

below threshold18.21931.03419No
